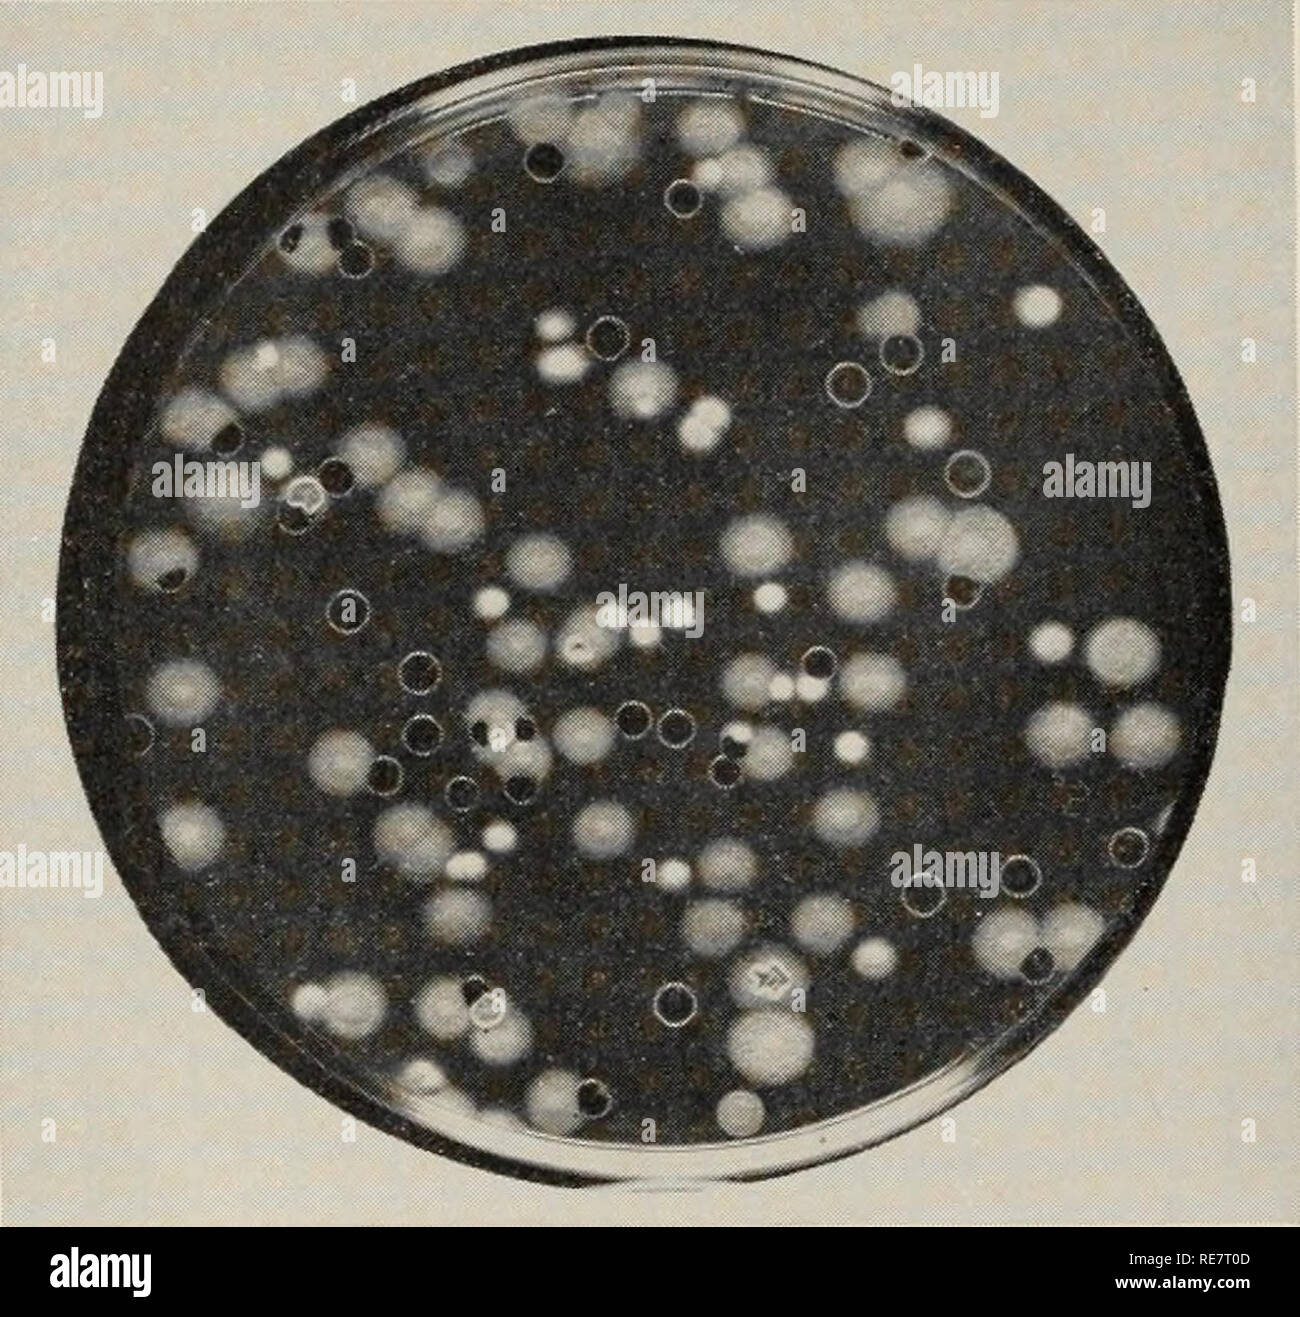
. Le charbon du maïs causée par l'Ustilago maydis. Le maïs ; maladies du charbon. Fig. 12. Une surface d'une plaque dispersés mono noir- sporidial ligne de l'Ustilago maydis cultivés dans une culture de pommes de terre-shake en dextrose agar. La ligne noire a donné lieu à plusieurs types de mutants blanc (Lu, 203). dans les facteurs de virulence, compatibilité, et la physiologie sans modification évidente des caractères culturels. Naturellement, les changements génétiques pour certains caractères morphologiques tels que la taille et le echinulation de chlamydo- les spores et les changements dans le parasitisme ne peut pas être ascer maintenu sans inoculation de l'hôte. La fréquence de mutation.-Alt Banque D'Images

Corn smut Photos Stock & Des Images
(91)Corn smut Photos Stock & Des Images
![. Les insectes affectant les légumes [microform]. Légumes ; légumes ; les insectes nuisibles ; insectes nuisibles. 44 Le maïs. Le charbon du maïs (j'stilago Zete). Cela est extrêmement fréquent di facilité, familier à tout producteur de maïs. Sur les tiges, feuilles, ta staminées salts, et les oreilles semblent crus particuliers, généralement décrits comme "se résume ces croissances sont blanc et le Polish<'d dans le stade précoce mais becor plus sombre en vieillissant. Ils sont remplis de spores noires qui produ. Fig. 52. U morts causés par le parasite ; < ;/Spore, hyphai encore attaché parent (oouidiophore). Un grand nombre de spores secondaires. Il s'agit de sp Banque D'Images . Les insectes affectant les légumes [microform]. Légumes ; légumes ; les insectes nuisibles ; insectes nuisibles. 44 Le maïs. Le charbon du maïs (j'stilago Zete). Cela est extrêmement fréquent di facilité, familier à tout producteur de maïs. Sur les tiges, feuilles, ta staminées salts, et les oreilles semblent crus particuliers, généralement décrits comme "se résume ces croissances sont blanc et le Polish<'d dans le stade précoce mais becor plus sombre en vieillissant. Ils sont remplis de spores noires qui produ. Fig. 52. U morts causés par le parasite ; < ;/Spore, hyphai encore attaché parent (oouidiophore). Un grand nombre de spores secondaires. Il s'agit de sp Banque D'Images](https://c8.alamy.com/compfr/ren46b/les-insectes-affectant-les-legumes-microform-legumes-legumes-les-insectes-nuisibles-insectes-nuisibles-44-le-mais-le-charbon-du-mais-j-stilago-zete-cela-est-extremement-frequent-di-facilite-familier-a-tout-producteur-de-mais-sur-les-tiges-feuilles-ta-staminees-salts-et-les-oreilles-semblent-crus-particuliers-generalement-decrits-comme-se-resume-ces-croissances-sont-blanc-et-le-polish-lt-d-dans-le-stade-precoce-mais-becor-plus-sombre-en-vieillissant-ils-sont-remplis-de-spores-noires-qui-produ-fig-52-u-morts-causes-par-le-parasite-lt-spore-hyphai-encore-attache-parent-oouidiophore-un-grand-nombre-de-spores-secondaires-il-s-agit-de-sp-ren46b.jpg)
RMREN46B–. Les insectes affectant les légumes [microform]. Légumes ; légumes ; les insectes nuisibles ; insectes nuisibles. 44 Le maïs. Le charbon du maïs (j'stilago Zete). Cela est extrêmement fréquent di facilité, familier à tout producteur de maïs. Sur les tiges, feuilles, ta staminées salts, et les oreilles semblent crus particuliers, généralement décrits comme "se résume ces croissances sont blanc et le Polish<'d dans le stade précoce mais becor plus sombre en vieillissant. Ils sont remplis de spores noires qui produ. Fig. 52. U morts causés par le parasite ; < ;/Spore, hyphai encore attaché parent (oouidiophore). Un grand nombre de spores secondaires. Il s'agit de sp

RMRD3W4C–. Cyclopedia de cultures agricoles : une étude des cultures populaires et des méthodes de récolte aux États-Unis et au Canada. Agriculture -- Canada, Agriculture -- United States ; produits de la ferme -- Canada ; produits de la ferme -- United States. Maïs Maïs Maïs 414 {tilago j'scharbon zea :) n un certain préjudice à presque chaque champ de blé. Elle réduit le nombre total annuel de la production de maïs des États-Unis par i)erhaps 2 %, ou, en d'autres termes, dans le réduit, sont issus de nos fermes vingt millions de dollars chaque année. Traitement de la semence, c'est d'aucune utilité. Les grappes de spores brunes ou noires qui se forment dans d'énormes masses sur différents par

RMRE03PW–. L'étude de la nature et de l'agriculture. L'étude de la nature ; l'Agriculture. 186 XATl'étude de RM et de l'agriculture du grain-chefs ou les épis de maïs. Charbon est un champignon poussant dans le corps de la tige et les feuilles, et lorsque les grains forme qu'il les saisit, les remplit de ses propres tissus et bientôt avec une masse de minute, spores noires. Quand le grain est battu, certains de ces spores adhèrent aux grains et sont plantés avec eux pour infecter la prochaine culture. Brun rouilles taches sur les feuilles et les tiges de céréales et de nombreuses autres plantes, souvent faire de grands dommages aux cultures. Le quiscale des taches sur la surface sont m

RMRDA8A4–. Le sud de grandes cultures (à l'exclusion des plantes fourragères). L'agriculture. 214 LE SUD DE GRANDES CULTURES Fungous, tandis que le plant de maïs est l'objet de quelques maladies, ce ne sont pas connus pour causer des blessures beaucoup dans le sud, à l'exception de ceux mentionnés ci-dessous, qui blessent principalement l'oreille. 195. Le maïs ( Ustilago mai- dis). - La présence de cette maladie est d'abord illustré par une grande enflure sur l'oreille, la tige, la panicule, ou la feuille (Fig. 108). Au début, cette masse en saillie est recouvert d'une peau blanchâtre, qui plus tard éclate, libérant des nuages de poudre noire. Ces particules poudreuses sont e

RMRE88BE–. La culture du maïs. Le maïs. 184 LE MAÏS. Planche 1.-charbon sur le maïs. Veuillez noter que ces images sont extraites de la page numérisée des images qui peuvent avoir été retouchées numériquement pour plus de lisibilité - coloration et l'aspect de ces illustrations ne peut pas parfaitement ressembler à l'œuvre originale.. Harry Potter, B. Fort Wayne, Ind. , correspondance Coll. de l'Agric.

RMRE4818–. Maïs ; son histoire, la culture, la manutention, et utilise, avec référence spéciale à l'Afrique du Sud ; un texte-livre pour les agriculteurs, les étudiants et les enseignants de l'agriculture, de l'étude de la nature. Maïs, maïs. Maïs 4io CHAP. X. sur la surface de l'envahi les pièces comme une masse de poussière noire. Pour citer M. Pole Evans (i, 2 et 3) : " La poudre noire ou de charbon est constitué d'une multitude d'organes de reproduction microscopique, com- monly connu comme les spores. Ils servent à propager le champignon et la maladie- dissemin,tand correspondent en fonction à graines dans les plantes supérieures. Chaque spore est brun et spheri- cal, et mesures

RMRDGBK2–. Les cultures de maïs : une discussion sur le maïs, et le sorgho comme kafirs, cultivé aux États-Unis et au Canada. Maïs, sorgho, maïs kafir. Animaux et d'INSECTES ENNEMIS 219. Fig. 73. Ââ épi de maïs montrant.. Veuillez noter que ces images sont extraites de la page numérisée des images qui peuvent avoir été retouchées numériquement pour plus de lisibilité - coloration et l'aspect de ces illustrations ne peut pas parfaitement ressembler à l'œuvre originale.. Montgomery, Edward Gerrard, 1878-. New York, The Macmillan Company

RMRE893N–. Enquêtes sur les maladies du maïs. Le maïs. 17 Q. Est-ce qu'il éradiquer tout de la maladie ? M. Funk : Ce serait mieux que de mettre le disaese dans le sol. Q. Allez-vous préserver autant de la fécondité en brûlant les branches que vous serez sous les labours ?. Intérieur de l'usine de maïs malades mal-note les pauvres racines et noeuds pourris. M. Funk : Oui, monsieur ; vous conserverez la fertilité mais vous perdrez l'humus. Vous pouvez vous permettre de perdre un peu d'humus pour se débarrasser de la maladie à l'heure actuelle. Q. Quand vous avez des tiges dans votre champ de maïs qui ont sur eux le charbon, que feriez-vous ?. Veuillez noter que le t
![. De plus en plus ; le maïs, de juger, de reproduction, d'alimentation, le marketing ;. Le maïs. Le charbon du maïs 217. Veuillez noter que ces images sont extraites de la page numérisée des images qui peuvent avoir été retouchées numériquement pour plus de lisibilité - coloration et l'aspect de ces illustrations ne peut pas parfaitement ressembler à l'œuvre originale.. Bowman, Melville Le Roy, 1881- [de l'ancien catalogue]. Waterloo, Iowa, vendu par Waterloo Publishing Co. Banque D'Images . De plus en plus ; le maïs, de juger, de reproduction, d'alimentation, le marketing ;. Le maïs. Le charbon du maïs 217. Veuillez noter que ces images sont extraites de la page numérisée des images qui peuvent avoir été retouchées numériquement pour plus de lisibilité - coloration et l'aspect de ces illustrations ne peut pas parfaitement ressembler à l'œuvre originale.. Bowman, Melville Le Roy, 1881- [de l'ancien catalogue]. Waterloo, Iowa, vendu par Waterloo Publishing Co. Banque D'Images](https://c8.alamy.com/compfr/re87px/de-plus-en-plus-le-mais-de-juger-de-reproduction-d-alimentation-le-marketing-le-mais-le-charbon-du-mais-217-veuillez-noter-que-ces-images-sont-extraites-de-la-page-numerisee-des-images-qui-peuvent-avoir-ete-retouchees-numeriquement-pour-plus-de-lisibilite-coloration-et-l-aspect-de-ces-illustrations-ne-peut-pas-parfaitement-ressembler-a-l-oeuvre-originale-bowman-melville-le-roy-1881-de-l-ancien-catalogue-waterloo-iowa-vendu-par-waterloo-publishing-co-re87px.jpg)
RMRE87PX–. De plus en plus ; le maïs, de juger, de reproduction, d'alimentation, le marketing ;. Le maïs. Le charbon du maïs 217. Veuillez noter que ces images sont extraites de la page numérisée des images qui peuvent avoir été retouchées numériquement pour plus de lisibilité - coloration et l'aspect de ces illustrations ne peut pas parfaitement ressembler à l'œuvre originale.. Bowman, Melville Le Roy, 1881- [de l'ancien catalogue]. Waterloo, Iowa, vendu par Waterloo Publishing Co.

RMRE3TKF–. De plus en plus ; le maïs, de juger, de reproduction, d'alimentation, le marketing ; pour l'agriculteur, étudiant et enseignant de l'agriculture, un manuel pour l'enseignement agricole et des shcools. Le maïs. Le charbon du maïs 217. Veuillez noter que ces images sont extraites de la page numérisée des images qui peuvent avoir été retouchées numériquement pour plus de lisibilité - coloration et l'aspect de ces illustrations ne peut pas parfaitement ressembler à l'œuvre originale.. Bowman, Melville Le Roy, 1881-. Waterloo, IA , vendus par Waterloo Publishing Co.

RMRDE1H2–. Un texte-livre de mycologie et pathologie des plantes . Les maladies des plantes ; champignons dans l'agriculture ; maladies des plantes ; les champignons. Compte rendu détaillé DE CERTAINES MALADIES DES PLANTES 505 Chaque cellule de qui produit une basidiospore. L'infection des tissus naissant à n'importe quelle partie de la plante la culture du maïs est accompUshed par la. Fig. 179.-bouillir de charbon Ustilago zea sur l'épi de blé, développé à partir d'un noyau4 infecte. (Après Jackson, F. S., Bull. 83, Del. Coll. Agric. Expér. Lattes., Décembre, 1908.) les basidiospores et non par les chlamydospores (Fig. 181). Le temps humide est essentiel pour la croissance du maïs et du charbon aussi.. Moyen

RMRDE1GK–. Un texte-livre de mycologie et pathologie des plantes . Les maladies des plantes ; champignons dans l'agriculture ; maladies des plantes ; les champignons. 5p6 pathologie végétale spéciale La maladie peut être contrôlée en retirant les smutted plantes de la matière et de les détruire et aussi par une rotation des cultures.. Fig. i8o.-charbon du maïs sur les glands de maïs sucré. {Après Jackson, F. S., Bull. 83, Del. Coll. Agric. Expér. Lattes., Décembre, 1908.) Comme le champignon peut infecter les plantes adultes, le traitement de la semence à l'aide de fongicides a été un échec. La rotation des cultures permet de maintenir également dans l'vérifier.. Veuillez noter que ces images sont e

RMRDYRPB–. Principes de la biologie moderne. La biologie. Fig. 31-17. Le maïs, maïs infecté par l'Ustilago zeae (charbon), un autre basidiomycète parasitaire. (Photo de Benjamin Koehler ; à partir de l'usine Monde.) des groupes, en particulier les gymnospermes et angiospermes, enfin une fertiliza ont évolué- tion dans laquelle les spermatozoïdes n'ont pas besoin d'eau pendant qu'elles sont transmises à l'œufs (Chap. 12). Embryons végétaux et leur protection. Le deuxième problème-nourrir le zygote pendant les premiers stades de développement vulnérables- ont commencé à atteindre une solution très tôt. Tous les em- classe (voir ci-dessous) sont caractérisées par la pos

RMRDYRPE–. Principes de la biologie moderne. La biologie. 610 - L'hérédité et de l'évolution. Fig. 31-17. Le maïs, maïs infecté par l'Ustilago zeae (charbon), un autre basidiomycète parasitaire. (Photo de Benjamin Koehler ; à partir de l'usine Monde.) des groupes, en particulier les gymnospermes et angiospermes, enfin une fertiliza ont évolué- tion dans laquelle les spermatozoïdes n'ont pas besoin d'eau pendant qu'elles sont transmises à l'œufs (Chap. 12). Embryons végétaux et leur protection. Le deuxième problème-nourrir le zygote pendant les premiers stades de développement vulnérables- ont commencé à atteindre une solution très tôt. Tous les em- classe (voir ci-dessous

RMRE1XA9–. La botanique pratique. La botanique. 242 PEACTICAL ( Ustilago Maïs botanique' Zece) infeste beaucoup des plantes de maïs dans un champ, et lorsque l'usure de l'espèce le charbon peu attrayants apparaissent fréquemment des masses. Le plus souvent, ils apparaissent dans les panicules ou l'oreille, et peut détruire complètement ou partiellement les deux (Fig. 197).J . 232. Les rouilles. Les structures complexes et les habitudes de vie de la rouille sont des objets de grand intérêt à bota- nists. Leur effet sur les plantes utiles et décoratifs qui servent de leurs hôtes leur donne une grande importance économique. Une espèce donnée de la rouille peut vivre pendant un ti

RMRE7T10–. Le charbon du maïs causée par l'Ustilago maydis. Le maïs ; maladies du charbon. Fig. 5. A) plant de maïs inoculés avec l'Ustilago maydis par la seringue hypodermique-méthode ; infection impliquant près de l'ensemble de l'usine. B) Xaturallv plante infectée, montrant des feuilles et de la tige (infection Stakman et Christensen, 311). devient infecté, le pédoncule et les panicules souvent se penche sur le côté. Les ovaires sont parfois développés dans la panicule de maïs et peuvent produire des semences normales. Certains travailleurs être- lieve charbon que l'infection dans la stimu- lates tassel effectivement le développement des ovaires dans la panicule. Ainsi. il rend le plus tassel

RMRDE68H–. Amis et ennemis de la ferme agricole : un texte-livre de science agricole . Les ravageurs agricoles ; les insectes utiles ; les insectes nuisibles. 228 AMIS DE LA FERME ET LES ENNEMIS avec cette maladie les grains individuels de blé sont concernés plutôt que de l'ensemble de la tête. Ces grains blanchâtres apparaissent ou blanchis par contraste avec le jaune des grains sains. Le charbon du maïs et de l'oignon le charbon curieusement enflé 2.2 sur les oreilles de maïs indien touchées par le charbon sont probablement familiers à chaque garçon ou fille élevée dans le pays. Le gonflement est dû à la croissance d'un champignon parasite qui se développe parmi les tissus- croître,

RMRECBJT–. Les plantes de la drogue de l'Illinois. La botanique, médical, la botanique. USTILAGO ZEAE. Le charbon du maïs. Usti- laginaceae.-un champignon parasite sur le maïs (Zea mays L.) apparaissant comme de grandes masses ou les gales de noir, poudre de suie sur les oreilles, les noeuds de la tige, et glands, et petites à grandes pustules sur toutes les autres parties de la plante. Les galles de la grand les oreilles, des tiges et des glands sont recueillies. Abondante dans les champs de maïs dans tout l'état. Contient des résines, mazenic, acide et l'alcaloïde ustalagine. Utilisé comme une ecbolic et antihemorrhagic. VALERIANA officinalis L. Heliotrope, valériane commune, jardin heliotrope. Valérianacées

RMRDF97M–. Grandes cultures pour la ceinture en coton. L'agriculture. Ennemis ET MALADIES DU MAÏS 271 ^d'importance sont ceux de maïs (Zea) charbon Ustilago et différentes sortes de ear-rots. 327. Le charbon du maïs -(Fig. 45) provoque souvent d'énormes en- largements sur l'oreille, Tassel, ou de la tige de la plante de maïs. L'infection n'apparaissent généralement pas avant l'plaflts sont un pied ou plus élevé. Les spores de la maladie sont reportés dans le sol de sorte que lorsque la terre est infectée par le charbon du maïs il est susceptible de causer un dommage à la récolte chaque année, à moins que certaines autres cultures que le maïs cultivé, ou à moins que des précautions sont prises pour découper et graver tous les j

RMRD3JKG–. Cyclopedia de cultures agricoles. Produits agricoles ; l'Agriculture. Maïs Maïs Maïs 414 charbon nu (Ustilago) zcm n un certain préjudice à presque chaque champ de blé. Elle réduit le nombre total annuel de la production de maïs des États-Unis par peut-être 2 %, ou, en d'autres termes, dans le réduit, sont issus de nos fermes vingt millions de dollars chaque année. Traitement de la semence, c'est d'aucune utilité. Les grappes de spores brunes ou noires qui se forment dans d'énormes masses sur difl^érentes parties du plant de maïs contiennent des millions de spores qui n'affectent pas les autres plantes directement, mais qui entraînent le champignon passe l'hiver et se développent dans le fumier en décomposition ou

RMRDR3T3–. Cyclopedia de cultures agricoles, une étude des cultures populaires et des méthodes de récolte aux États-Unis et au Canada ;. Produits agricoles ; l'Agriculture. Maïs Maïs Maïs 414 UstUago charbon (zem) n un certain préjudice à presque chaque champ de blé. Elle réduit le nombre total annuel de la production de maïs des États-Unis par peut-être 2 %, ou, en d'autres termes, dans le réduit, sont issus de nos fermes vingt millions de dollars chaque année. Traitement de la semence, c'est d'aucune utilité. Les grappes de spores brunes ou noires qui se forment dans d'énormes masses sur différentes parties de la plante de maïs contiennent des millions de spores qui n'affectent pas d'autres plantes dire

RMRDJ612–. Fungous les maladies des plantes : avec des chapitres sur la physiologie, les méthodes de culture et de technique . Les champignons dans l'agriculture. 376 FUNGOUS LES MALADIES DES PLANTES où la maladie est très abondante il serait possible, sur plats d'être employé pour les semences, pour éliminer les plantes smutted avant leur échéance finale. La plus récente recommandation en ce qui concerne le traitement des semences est de faire tremper 5 heures dans de l'eau froide, puis dix minutes dans l'eau à 540 C. IV. De charbon Ustilago MAÏS Zea (Beckm.) Ung. Arthur, J. C, et Stuart W., charbon du maïs. Ind. AGL. Exp. Sta. Ann. Rept. 12 : 84-135. 1900. Hitchcock, A. S., et Norton, J. B. S

RMRE7T14–. Le charbon du maïs causée par l'Ustilago maydis. Le maïs ; maladies du charbon. Fig. 2. Schéma illustrant le cycle de vie d'Vslilago maydis. Il existe de nombreux types d'écart par rapport à celui donné, en particulier dans la germination des chlamydospores et mei- TSO (par C. M. Christensen). rien au sujet de l'État nucléaire, mode de formation, nature de la germination, ou d'une fonction dans le cycle de vie. La surcroissance smutty produit par l'U. maydis sur le maïs (Zea mays L.) et le téosinte (E. mexicana Schrad.) a été appelé par plusieurs noms communs : faire bouillir, blister, excroissance, gall, tumeur, sore, pustule. et de l'enflure. Jusqu'à 1900 environ. Le t

RMRE7T0Y–. Le charbon du maïs causée par l'Ustilago maydis. Le maïs ; maladies du charbon. Fig-. 6. Les jeunes plants de maïs, grièvement blessés par l'Ustilago maydis et prostré sur le sol, par conséquent soumis à désintégration rapide (Stakman et Christensen, 311). La même si inoculés avec du charbon non local ou local ; par conséquent, les collections races physiologiques n'apparaissent pas responsable (57). Il existe des preuves que certains caractères morphologiques, c.-à-d., l'absence de ligules et serré- ness de husk, peuvent être impliqués dans certains cas (157, 193 I. L'isolement de l'U. maydis.-cultures peuvent facilement être obtenus par l'ensemencement des chlamydospores sur 1-2 % pomme de terre-

RMRE7RYC–. Le charbon du maïs causée par l'Ustilago maydis. Le maïs ; maladies du charbon. Fig. 19. Les descendances haploïdes doublées de 3 séries de 4 lignes mono- sporidial tilago de I'Smaydis obtenues à partir de 3 chlamydospores hybride F, M et K, issu d'un croisement d'un mutant, K.,-1 avec la ligne L (Stakman, et al., 319). lorsqu'elle est injectée dans le maïs. Dans l'autre groupe, pas d'in- fection a abouti, même si la paire de lignes sporidial dans toutes les combinaisons possibles (55). Ce type de ségrégation pour l'auto-stérilité n'est pas rare dans l'U. maydis. Christensen (55) obtenu pas de galles en jumelant des 16 ensembles de lignes sporidial primaire lorsque tous les appariements possibles

RMRE7RYG–. Le charbon du maïs causée par l'Ustilago maydis. Le maïs ; maladies du charbon. Fig. 19. Les descendances haploïdes doublées de 3 séries de 4 lignes mono- sporidial tilago de I'Smaydis obtenues à partir de 3 chlamydospores hybride F, M et K, issu d'un croisement d'un mutant, K.,-1 avec la ligne L (Stakman, et al., 319). lorsqu'elle est injectée dans le maïs. Dans l'autre groupe, pas d'in- fection a abouti, même si la paire de lignes sporidial dans toutes les combinaisons possibles (55). Ce type de ségrégation pour l'auto-stérilité n'est pas rare dans l'U. maydis. Christensen (55) obtenu pas de galles en jumelant des 16 ensembles de lignes sporidial primaire lorsque tous les appariements possibles

RMRE7T12–. Le charbon du maïs causée par l'Ustilago maydis. Le maïs ; maladies du charbon. Fig. 4. Épis de maïs et gland touchés avec charbon. V apparemment en raison de l'infection par des bactéries et certains champignons. De plus, espèce de Rhizopus, Mucor, Aspergillus. Le Penicillium, et d'autres genres ne sont pas rares dans les galles de charbon du maïs. Les galles de charbon peuvent se développer sur une partie de la plante au-dessus du sol, là où l'agent pathogène de méristèmes de rencontres. Les galles sont généralement plus répandus sur les oreilles, de glands, de tiges, de pousses et de nœud. Sur certaines variétés, l'infection des feuilles est également très courant, particulièrement sur ou près de la nervure centrale, à la jonction de la
![. Le charbon du maïs causée par l'Ustilago maydis. Le maïs ; maladies du charbon. } 94 & ; % f. J ?. Veuillez noter que ces images sont extraites de la page numérisée des images qui peuvent avoir été retouchées numériquement pour plus de lisibilité - coloration et l'aspect de ces illustrations ne peut pas parfaitement ressembler à l'œuvre originale.. Christensen, J. J. (Jonas Jergon), 1892-1964. [Worcester, Mass. ] : American Phytopathological Society Banque D'Images . Le charbon du maïs causée par l'Ustilago maydis. Le maïs ; maladies du charbon. } 94 & ; % f. J ?. Veuillez noter que ces images sont extraites de la page numérisée des images qui peuvent avoir été retouchées numériquement pour plus de lisibilité - coloration et l'aspect de ces illustrations ne peut pas parfaitement ressembler à l'œuvre originale.. Christensen, J. J. (Jonas Jergon), 1892-1964. [Worcester, Mass. ] : American Phytopathological Society Banque D'Images](https://c8.alamy.com/compfr/re7t16/le-charbon-du-mais-causee-par-l-ustilago-maydis-le-mais-maladies-du-charbon-94-amp-f-j-veuillez-noter-que-ces-images-sont-extraites-de-la-page-numerisee-des-images-qui-peuvent-avoir-ete-retouchees-numeriquement-pour-plus-de-lisibilite-coloration-et-l-aspect-de-ces-illustrations-ne-peut-pas-parfaitement-ressembler-a-l-oeuvre-originale-christensen-j-j-jonas-jergon-1892-1964-worcester-mass-american-phytopathological-society-re7t16.jpg)
RMRE7T16–. Le charbon du maïs causée par l'Ustilago maydis. Le maïs ; maladies du charbon. } 94 & ; % f. J ?. Veuillez noter que ces images sont extraites de la page numérisée des images qui peuvent avoir été retouchées numériquement pour plus de lisibilité - coloration et l'aspect de ces illustrations ne peut pas parfaitement ressembler à l'œuvre originale.. Christensen, J. J. (Jonas Jergon), 1892-1964. [Worcester, Mass. ] : American Phytopathological Society

RMRE7T0T–. Le charbon du maïs causée par l'Ustilago maydis. Le maïs ; maladies du charbon. Fig. 7. Les dessins de caméra lucida : germination- mydospores absc de Ustilago maydis, montrant divers types de germination (Kernkamp et Petty, 182). Environ 10 C pour un an ou deux sans perdre sa viabilité. Les chlamydospores perdent leur viabilité dans l'ensilage après quelques semaines (260). Cela peut également se produire lorsqu'ils sont mélangés avec du fumier, en particulier si la fermentation ou de chauffage a lieu ; ou si les spores entrent en contact avec les agents destructeurs tels que les acides, alcalis, et d'antibiotiques. Il est généralement admis que des sporidies mul- tiply et persi
![. Le charbon du maïs causée par l'Ustilago maydis. Le maïs ; maladies du charbon. Fig. 9. Variabilité phénotypique dans l'Ustilago maydis en raison de différences dans les éléments nutritifs. Les colonies en double d'une ligne de monosporidiennes C. maydis sur 3 supports différents (Stakman, et al., 314).. Veuillez noter que ces images sont extraites de la page numérisée des images qui peuvent avoir été retouchées numériquement pour plus de lisibilité - coloration et l'aspect de ces illustrations ne peut pas parfaitement ressembler à l'œuvre originale.. Christensen, J. J. (Jonas Jergon), 1892-1964. [Worcester, Mass. ] : American Phytopathological Society Banque D'Images . Le charbon du maïs causée par l'Ustilago maydis. Le maïs ; maladies du charbon. Fig. 9. Variabilité phénotypique dans l'Ustilago maydis en raison de différences dans les éléments nutritifs. Les colonies en double d'une ligne de monosporidiennes C. maydis sur 3 supports différents (Stakman, et al., 314).. Veuillez noter que ces images sont extraites de la page numérisée des images qui peuvent avoir été retouchées numériquement pour plus de lisibilité - coloration et l'aspect de ces illustrations ne peut pas parfaitement ressembler à l'œuvre originale.. Christensen, J. J. (Jonas Jergon), 1892-1964. [Worcester, Mass. ] : American Phytopathological Society Banque D'Images](https://c8.alamy.com/compfr/re7t0j/le-charbon-du-mais-causee-par-l-ustilago-maydis-le-mais-maladies-du-charbon-fig-9-variabilite-phenotypique-dans-l-ustilago-maydis-en-raison-de-differences-dans-les-elements-nutritifs-les-colonies-en-double-d-une-ligne-de-monosporidiennes-c-maydis-sur-3-supports-differents-stakman-et-al-314-veuillez-noter-que-ces-images-sont-extraites-de-la-page-numerisee-des-images-qui-peuvent-avoir-ete-retouchees-numeriquement-pour-plus-de-lisibilite-coloration-et-l-aspect-de-ces-illustrations-ne-peut-pas-parfaitement-ressembler-a-l-oeuvre-originale-christensen-j-j-jonas-jergon-1892-1964-worcester-mass-american-phytopathological-society-re7t0j.jpg)
RMRE7T0J–. Le charbon du maïs causée par l'Ustilago maydis. Le maïs ; maladies du charbon. Fig. 9. Variabilité phénotypique dans l'Ustilago maydis en raison de différences dans les éléments nutritifs. Les colonies en double d'une ligne de monosporidiennes C. maydis sur 3 supports différents (Stakman, et al., 314).. Veuillez noter que ces images sont extraites de la page numérisée des images qui peuvent avoir été retouchées numériquement pour plus de lisibilité - coloration et l'aspect de ces illustrations ne peut pas parfaitement ressembler à l'œuvre originale.. Christensen, J. J. (Jonas Jergon), 1892-1964. [Worcester, Mass. ] : American Phytopathological Society

RMRDCY9H–. La botanique pour les étudiants en agriculture . La botanique. Le charbon du maïs 395^ ^^-4 l'Escarbille d'avoine, de blé, de charbon puant et le charbon couvert d'orge sont très semblables dans l'habitude et exiger un traitement similaire. Parfois, comme dans le cas de charbon puant de blé, l'infec- tion de la plantule peut être dû à des spores déposées dans le sol ainsi qu'à des spores qui adhèrent au noyau. Smuts lâche de blé et d'orge. - Les charbons de blé et d'orge ont versé leur maturité et les chlamydospores lorsque le grain est en fleurs. Ces spores sont supportés par le vent et en tombant sur les fleurs de leurs hôtes respectifs, gro

RMRDWCXA–. La botanique, avec les applications agricoles. La botanique. Charbon Charbon le maïs 395 d'avoine, de blé, de charbon puant et le charbon couvert d'orge sont très semblables dans l'habitude et exiger un traitement similaire. Parfois, comme m cas du charbon puant de blé, l'infec- tion de la plantule peut être dû à des spores déposées dans le sol ainsi qu'à des spores qui adhèrent au noyau. Smuts lâche de blé et d'orge. - Les charbons de blé et d'orge ont versé leur maturité et les chlamydospores lorsque le grain est en fleurs. Ces spores sont supportés par le vent et quand falhng sur les fleurs de leurs hôtes respectifs, croître h

RMRE7T0P–. Le charbon du maïs causée par l'Ustilago maydis. Charbon ; maïs maladies. indique que la température optimale pour la germination des chlamydospores se situe entre 20 et 25 C. C'est aussi la température la plus favorable pour sporidial et le développement du mycélium. Mme Jones (175) obtenus résultats quelque peu différente : la température optimale est entre 26" et 34 C. maximum entre 56 et 38 : °C, et les spores germent à une faible mesure à ST. ce qui n'est pas nécessairement le minimum. Hiittig (153) trouvé la voiture- dinal températures pour la germination à être : minimum OC. optimum entre 20 et 50 C, et maximum juste en dessous

RMRDE691–. Amis et ennemis de la ferme agricole : un texte-livre de science agricole . Les ravageurs agricoles ; les insectes utiles ; les insectes nuisibles. Chapitre XX Les champignons les charbons forment un groupe distinctif de plantes parasites appelés par les botanistes Ustilaginales. Le mycélium se développe dans les tissus de la plante hôte et les causes des blessures graves pour les parties infestées. Les spores sont développées sous la forme de la poudre noire si caractéristique de charbon du maïs et l'avoine. Ces spores germent sous conditions favorable et souvent aboutir à l'élaboration d'un très grand nombre de spores secondaires. Presque chaque un

RMRE0M5G–. Des expériences avec des plantes. La botanique. Les végétaux qui CA CUJi' DEOA Y 397 sur lequel elles poussent l peuvent être protégés contre les aliments tliem de la même manière que contre l'bacteiia ? ^ une immense quantité de dégâts, s'élevant dans les seuls États-Unis à un très grand nombre de miUions de dollars chaque année, est fait aux récoltes par les charbons, rouille et mildiou. Pour cette raison et pour d'autres il vaut la peine de consacrer une étude à ces plantes, afin que nous puissions mieux comprendre leur mode de vie et les meilleurs remèdes contre l'theui. Le charbon du maïs commun commence à apparaître dans les feuilles lorsque la plante est de trois ou quatre pieds
![. Le charbon du maïs causée par l'Ustilago maydis. Le maïs ; maladies du charbon. Lbtilago zeae (crou) - 50' (porenty^T ]Z 18 (Hi) sporidial 10 Kz., (mycélium) germant F, chlamydospores. Fig. 21. Types de croissance mycélienne et sporidial les parents et des chlamydospores Fx en germination montrant différences dans la production des sporidies et hvphal branches (Kernkamp, 179.) si fréquemment muté ségrégants du noir au blanc et de couleurs intermédiaires qu'il était impossible de déterminer le nombre de facteurs impliqués dans l'en- heritance de couleur (Fig. 201. Lu résultats suggèrent qu'il serait hautement souhaitable de faire Banque D'Images . Le charbon du maïs causée par l'Ustilago maydis. Le maïs ; maladies du charbon. Lbtilago zeae (crou) - 50' (porenty^T ]Z 18 (Hi) sporidial 10 Kz., (mycélium) germant F, chlamydospores. Fig. 21. Types de croissance mycélienne et sporidial les parents et des chlamydospores Fx en germination montrant différences dans la production des sporidies et hvphal branches (Kernkamp, 179.) si fréquemment muté ségrégants du noir au blanc et de couleurs intermédiaires qu'il était impossible de déterminer le nombre de facteurs impliqués dans l'en- heritance de couleur (Fig. 201. Lu résultats suggèrent qu'il serait hautement souhaitable de faire Banque D'Images](https://c8.alamy.com/compfr/re7ry7/le-charbon-du-mais-causee-par-l-ustilago-maydis-le-mais-maladies-du-charbon-lbtilago-zeae-crou-50-porenty-t-z-18-hi-sporidial-10-kz-mycelium-germant-f-chlamydospores-fig-21-types-de-croissance-mycelienne-et-sporidial-les-parents-et-des-chlamydospores-fx-en-germination-montrant-differences-dans-la-production-des-sporidies-et-hvphal-branches-kernkamp-179-si-frequemment-mute-segregants-du-noir-au-blanc-et-de-couleurs-intermediaires-qu-il-etait-impossible-de-determiner-le-nombre-de-facteurs-impliques-dans-l-en-heritance-de-couleur-fig-201-lu-resultats-suggerent-qu-il-serait-hautement-souhaitable-de-faire-re7ry7.jpg)
RMRE7RY7–. Le charbon du maïs causée par l'Ustilago maydis. Le maïs ; maladies du charbon. Lbtilago zeae (crou) - 50' (porenty^T ]Z 18 (Hi) sporidial 10 Kz., (mycélium) germant F, chlamydospores. Fig. 21. Types de croissance mycélienne et sporidial les parents et des chlamydospores Fx en germination montrant différences dans la production des sporidies et hvphal branches (Kernkamp, 179.) si fréquemment muté ségrégants du noir au blanc et de couleurs intermédiaires qu'il était impossible de déterminer le nombre de facteurs impliqués dans l'en- heritance de couleur (Fig. 201. Lu résultats suggèrent qu'il serait hautement souhaitable de faire

RMRE7T0F–. Le charbon du maïs causée par l'Ustilago maydis. Le maïs ; maladies du charbon. Variabilité phénotypique et mutations constituent un obstacle considérable à des études précises sur la physiologie et l'héritage d'études U. maydis. Mutation.-cultures de masse d'U. maydis souvent non pathogènes deviennent après beaucoup de transferts sur un solide substrat artificiel. De tels changements ont été re- porté avant qu'il s'est rendu compte qu'est l'U. maydis (59 hétérothallique. 312). Nous savons maintenant de l'ex- periments que les variantes pourraient être dues à la sélection de lignes unisexuées une population mixte plutôt qu'en raison de mutants. Depuis 1927, des études sur transformation

RMRD3JMX–. Cyclopedia de cultures agricoles. Produits agricoles ; l'Agriculture. 625. Le charbon du maïs. (Page 414.) taille de l'oreille d'un écureuil ou le cornouiller sont en fleurs, c'est comme une date précise qu'il est possible de l'établir. Le taux de plantation est également un point qui doit être réglée pour chaque localité et chaque sol particulier. Pour les sols très fertiles, les distances sont généralement adoptée 3J x 3j les pieds, avec trois noyaux par hill. Lorsqu'il est planté à ce rythme, le pied à l'automne devrait se situer en moyenne au moins deux tiges et demi par Hill, et, avec ce support, les rendements de 100 boisseaux par acre et plus sont possibles. r '"'S*

RMRE7RYJ–. Le charbon du maïs causée par l'Ustilago maydis. Le maïs ; maladies du charbon. Fig. 17. Sporidial fusion dans l'Ustilago maxdis (Brefeld, 34). Les facteurs culturels durant le stade végétatif d'U. maydis &Lt ; 145 i. En fait. Holliday a conclu que le crossing-over mitotique se produit dans les lignes diploïdes, bien qu'ils sont apparemment rares, et la plupart des échanges sont célibataires. Il a augmenté la fréquence de croisement mitotique- plus de par le rayonnement ultraviolet (145). Nombre de chromosomes.-La plupart des chercheurs en- dicate qu'il est difficile de déterminer le nombre de chromosomes dans U. maydis (55, 58, 85). Les noyaux de l'U. maydis sont petites

RMRE7RYN–. Le charbon du maïs causée par l'Ustilago maydis. Charbon ; maïs maladies. un chlamydospore peut contenir 2 noyaux. Ehrlich (85) a observé des chlamydospores binuclées et études cytologiques a indiqué que le 2 pourrait être soit des noyaux haploïdes ou diploïdes 2 2 ou un de chaque. Certaines donnent lieu à des chlamydospores promycéliums 2. D'une spore, cultures monosporidiennes- tinct de 5 types ont été isolées (55). Cela aurait pu être le produit d'un chlamydospore avec plus d'un noyau ou le résultat d'une mutation. Réduction différée.-U. maydis méiose ne se produit pas toujours de manière régulière. Facteurs de ségrégation pour s

RMRE7T07–. Le charbon du maïs causée par l'Ustilago maydis. Le maïs ; maladies Charbon. lignes d'U. maydis qui ont été dérivés de 4 membres est différente sur des substrats solides. En Mutation 5 media, le plus grand nombre a été sur 3C'C le sucrose agar contenant 0.006 ro NaN03. Les nitrate de sodium et le nitrate de calcium stimule la mutation, alors que le phosphate d'ammonium semble inhiber la mutation. Gattani (111) a tenté d'augmenter la fréquence de la mutation de ce qui suit sous- stances nocives de pomme de terre-dextrose agar : nitrate de plomb, le vert de malachite, chlorure de potassium, nitrate de bismuth, fer à repasser sul- fate, le chlorure mercurique,

RMRE03G1–. Les maladies du bétail, moutons, chèvres et porcs. La médecine vétérinaire. 224 un empoisonnement. USTILAGINACEiE (l-i:lDT FAMILLE). L'Ustilago maydis.-Le champignon blanc noir connu sous le nom de charbon du maïs est commun le rl'oughout les com-producmg districts du centre des États-Unis, et est parfois considérée comme fatale à stock. Des expériences faites dans le Wisconsin et ailleurs montrent qu'il n'est pas un poison très actif lorsqu'elle est consommée en quantité modérée. Lorsqu'il est administré en augmentant progressivement les montants jusqu'à 2 lbs., aucun effet n'a été noté, mais 4 livres sur chacun de deux jours ont causé la mort subite d'une vache. Comme le maïs.
RMRE7T0D–. Le charbon du maïs causée par l'Ustilago maydis. Le maïs ; maladies du charbon. Fig. 12. Une surface d'une plaque dispersés mono noir- sporidial ligne de l'Ustilago maydis cultivés dans une culture de pommes de terre-shake en dextrose agar. La ligne noire a donné lieu à plusieurs types de mutants blanc (Lu, 203). dans les facteurs de virulence, compatibilité, et la physiologie sans modification évidente des caractères culturels. Naturellement, les changements génétiques pour certains caractères morphologiques tels que la taille et le echinulation de chlamydo- les spores et les changements dans le parasitisme ne peut pas être ascer maintenu sans inoculation de l'hôte. La fréquence de mutation.-Alt

RMRE2FGN–. Principes de botanique. La botanique. IMPORTANCE ÉCONOMIQUE 299 OE EUNGI tige, la fructification dans les tissus, et fréquemment de détruire le grain de céréale. Les innombrables spores noires forment une poudre de suie-d'où le nom commun de "charbon.". Fig. 221.-maïs-{charbon Ustilago maydis)..sur tige, Tassel, l'oreille, et feuille de Zea mays. 286. Les rouilles.-L'histoire de l'EFU le {la rouille du blé Puc- cinia graminis) a été indiqué au chapitre XIX. Ce champignon n'a pas seulement causé des millions de dollars de dommages à la récolte de blé du monde mais a été la cause de textes législatifs. Dès 1760 il a été adopté

RMRE7T0A–. Le charbon du maïs causée par l'Ustilago maydis. Le maïs ; maladies du charbon. Fig. 12. Une surface d'une plaque dispersés mono noir- sporidial ligne de l'Ustilago maydis cultivés dans une culture de pommes de terre-shake en dextrose agar. La ligne noire a donné lieu à plusieurs types de mutants blanc (Lu, 203). dans les facteurs de virulence, compatibilité, et la physiologie sans modification évidente des caractères culturels. Naturellement, les changements génétiques pour certains caractères morphologiques tels que la taille et le echinulation de chlamydo- les spores et les changements dans le parasitisme ne peut pas être ascer maintenu sans inoculation de l'hôte. La fréquence de mutation.-Alt

RMRE7T0H–. Le charbon du maïs causée par l'Ustilago maydis. Le maïs ; maladies du charbon. Fig. 9. Variabilité phénotypique dans l'Ustilago maydis en raison de différences dans les éléments nutritifs. Les colonies en double d'une ligne de monosporidiennes C. maydis sur 3 supports différents (Stakman, et al., 314).. Fig. 10. Sept mutants de l'Ustilago maydis d'une ligne d'haploïdes dérivés comme séparer des diploïdes ; une ligne parent en haut à gauche. Encore une fois les mutants sectorisation (Christensen, 55). 22. Veuillez noter que ces images sont extraites de la page numérisée des images qui peuvent avoir été retouchées numériquement pour plus de lisibilité - coloration et l'aspect de ces illustration

RMRDD1PY–. Le livre du maïs : un traité complet sur la culture, la commercialisation et les utilisations du maïs en Amérique latine et ailleurs, pour les agriculteurs, les négociants, les fabricants et autres : un manuel complet sur la production, la vente, l'utilisation et du commerce des cultures de plus grande du monde . Le maïs. Les nouvelles utilisations du maïs 315 Valeur comptable des couleurs dans l'impression de tissu. Différents grades ot d'amidon, de blanchisserie, de comestibles sont également produites. Ces produits peuvent être considérés comme le principal ou. Fig 94-épi de maïs Smutted Cette oreille est touchée, avec seulement le charbon à l'extrémité où il était imparfaitement couverts par la balle. A partir de Photo prêtée par l'INDI

RMRDY5XX–. Botanique de la plante vivante. La botanique. 450 BOTANIQUE DE LA PLANTE VIVANT LISTILAGINEAE (SmUTS) . Le Smut-Fungi Ustilagineae () sont également des parasites sur les graminées, certaines maladies causant les lo sur l'avoine, orge, blé et maïs, qui culminent dans l'oreille de fructification. Les grains malades est remplacé par une masse de spores sombre, correspondant à leur comportement à l'teleuto-spores du Uredineae (Fig. 385). Pour les hke elles germent après l'hiver de repos, formant une hasidium (promycélium) avec carpospores infectieux sporidies (). Ils ont été montré pour être en mesure d'infecter les semis du maïs-plante

RMRE2FGR–. Principes de botanique. La botanique. 298 histoires de vie et la structure de ces maladies sont causées par des champignons du genre Ustilago} Les espèces sont souvent nommés à partir de la plante affectée, par exemple l'Ustilago Avenm sur l'avoine (Avena, fig. 220),. Fig. 220.-Panicules de l'avoine (Avena sativa), avec les grains presque com- plètement détruite et remplacée par le {charbon d'avoine Avena Ustilago). Ustilago Triticl sur orge (Triticum), Ustilago ZecB {sur le maïs Zea, fig. 221). Le mycélium s'étend sur les 1 UNE Hemibasidiomycete.. Veuillez noter que ces images sont extraites de la page numérisée des images qui peuvent avoir été digitall

RMRDE30C–. Les maladies des plantes d'importance économique . Les maladies des plantes. 332 LES MALADIES DES PLANTES ÉCONOMIQUES brane finalement éclate, desserrant un blanc, sec, messe noire de spores par lequel les veines fibreuses de l'usine de meubles com- trate. Il a été d'une manière concluante que le onstrated- dem champignon causal n'est pas transmis à la nouvelle culture dans la semence, comme c'est le cas de tant d'autres charbons, et que, par conséquent, aucune forme de traitement de semences est de valeur pour ses pré- vention. L'ét- tion de semences couvertes de spores de charbon n'entraîne pas de charbon plus que ne l'utilisation d'onu- les semences infectées. Il a été clairement montré que l'infec-

RMRD3W5A–. Cyclopedia de cultures agricoles : une étude des cultures populaires et des méthodes de récolte aux États-Unis et au Canada. Agriculture -- Canada, Agriculture -- United States ; produits de la ferme -- Canada ; produits de la ferme -- United States. Fig. 625. Com. (Page 414.) taille de l'oreille d'un écureuil ou le cornouiller sont en fleurs, c'est comme une date précise qu'il est possible de l'établir. Le taux de plantation est également un point qui doit être réglée pour chaque localité et chaque sol particulier. Pour les sols très fertiles, les distances sont généralement adoptée 3^ 3x je pieds, avec trois noyaux par hill. "Lorsqu'il est planté à ce rythme, le

RMRDCCYB–. La vie des plantes et des sols liés à l'agriculture . L'agriculture, le sol, les plantes. La propagation de plantes 125. Fig. 44. - Le charbon au oreille de maïs.. Veuillez noter que ces images sont extraites de la page numérisée des images qui peuvent avoir été retouchées numériquement pour plus de lisibilité - coloration et l'aspect de ces illustrations ne peut pas parfaitement ressembler à l'œuvre originale.. Cunningham, Jules Cool, 1879- ; Lancelot, William Henry, 1874-. New York : Macmillan
![. De plus en plus ; le maïs, de juger, de reproduction, d'alimentation, le marketing ;. Le maïs. Stérilité CAUSÉE PAR LA MALADIE 447 le pas à l'écart dans une mesure de laisser les tiges affaiblies et par conséquent stérile.. PLANT DE MAÏS AFFECTÉS PAR DANS DIVERS ENDROITS.. Veuillez noter que ces images sont extraites de la page numérisée des images qui peuvent avoir été retouchées numériquement pour plus de lisibilité - coloration et l'aspect de ces illustrations ne peut pas parfaitement ressembler à l'œuvre originale.. Bowman, Melville Le Roy, 1881- [de l'ancien catalogue]. Waterloo, Iowa, vendu par Waterloo Publishing Co. Banque D'Images . De plus en plus ; le maïs, de juger, de reproduction, d'alimentation, le marketing ;. Le maïs. Stérilité CAUSÉE PAR LA MALADIE 447 le pas à l'écart dans une mesure de laisser les tiges affaiblies et par conséquent stérile.. PLANT DE MAÏS AFFECTÉS PAR DANS DIVERS ENDROITS.. Veuillez noter que ces images sont extraites de la page numérisée des images qui peuvent avoir été retouchées numériquement pour plus de lisibilité - coloration et l'aspect de ces illustrations ne peut pas parfaitement ressembler à l'œuvre originale.. Bowman, Melville Le Roy, 1881- [de l'ancien catalogue]. Waterloo, Iowa, vendu par Waterloo Publishing Co. Banque D'Images](https://c8.alamy.com/compfr/re87dc/de-plus-en-plus-le-mais-de-juger-de-reproduction-d-alimentation-le-marketing-le-mais-sterilite-causee-par-la-maladie-447-le-pas-a-l-ecart-dans-une-mesure-de-laisser-les-tiges-affaiblies-et-par-consequent-sterile-plant-de-mais-affectes-par-dans-divers-endroits-veuillez-noter-que-ces-images-sont-extraites-de-la-page-numerisee-des-images-qui-peuvent-avoir-ete-retouchees-numeriquement-pour-plus-de-lisibilite-coloration-et-l-aspect-de-ces-illustrations-ne-peut-pas-parfaitement-ressembler-a-l-oeuvre-originale-bowman-melville-le-roy-1881-de-l-ancien-catalogue-waterloo-iowa-vendu-par-waterloo-publishing-co-re87dc.jpg)
RMRE87DC–. De plus en plus ; le maïs, de juger, de reproduction, d'alimentation, le marketing ;. Le maïs. Stérilité CAUSÉE PAR LA MALADIE 447 le pas à l'écart dans une mesure de laisser les tiges affaiblies et par conséquent stérile.. PLANT DE MAÏS AFFECTÉS PAR DANS DIVERS ENDROITS.. Veuillez noter que ces images sont extraites de la page numérisée des images qui peuvent avoir été retouchées numériquement pour plus de lisibilité - coloration et l'aspect de ces illustrations ne peut pas parfaitement ressembler à l'œuvre originale.. Bowman, Melville Le Roy, 1881- [de l'ancien catalogue]. Waterloo, Iowa, vendu par Waterloo Publishing Co.

RMREY8H1–. Catalogue des produits de l'agriculture et de l'horticulture ... 32 outils agricoles et horticoles. Ventilation améliorée. Smut-Machine. Cette machine a été en usage depuis 1838. Certains d'entre eux ont exécuté sept ans sans réparation, antl worii à tous égards ainsi que lorsque d'abord mettre en place. Ces machines sont justifier par l'inventeur à excel tous les autres dans l'utilisation, et de donner par affec- satisfaction. Les prix varient selon les formats, capa- cité, ou d'attaché. Nous avons divers autres types et tailles. Fig. 33. Écorce-MILL, ET LE MAÏS ET COB-Bark-Mill* concasseurs.. Veuillez noter que ces images sont e

RMRDWNFW–. Science de la vie végétale, une école botanique le traitement de la plante et de son rapport à l'environnement. La botanique. 266 Science de la vie des plantes hôtes les plantes sont l'oie sauvage et cultivé- les petits fruits et les raisins de Corinthe. Une autre rouille est fréquemment vue sur la framboise et mûriers le long des routes ; il colore les imder faces des feuilles avec ses chambres lumineuses, orange-rouge des spores. Les charbons. Les charbons de l'avoine, blé, orge, maïs et souvent de réduire considérablement le rendement de ces plantes. Mais depuis leurs histoires Hfe sont connus, il est coinpara- ment facile de les contrôler. Les champignons generall

RMRE3T3R–. De plus en plus ; le maïs, de juger, de reproduction, d'alimentation, le marketing ; pour l'agriculteur, étudiant et enseignant de l'agriculture, un manuel pour l'enseignement agricole et des shcools. Le maïs. Stérilité CAUSÉE PAR LA MALADIE 447 le pas à l'écart dans une mesure de laisser les tiges affaiblies suis par conséquent stérile.. PLANT DE MAÏS AFFECTÉS PAR DANS DIVERS ENDROITS.. Veuillez noter que ces images sont extraites de la page numérisée des images qui peuvent avoir été retouchées numériquement pour plus de lisibilité - coloration et l'aspect de ces illustrations ne peut pas parfaitement ressembler à l'œuvre originale.. Bowman, Melville Le Roy, 1881-. Waterloo,

RMRF1P2P–. Catalogue de graines cultivées. Le jardinage United States de l'équipement et des fournitures ; les catalogues de graines de legumes United States catalogues ; graines de fleurs United States catalogues ; Graines Fruits United States catalogues ; graines de céréales ; les outils de jardinage Catalogues Catalogues. Cory Cokn blanc. La bonne terre et Cory variétés', que nous avons lancé il y a quelques années, n'ont pas encore été dépassé dans la précocité ; mais les laquais du maïs, qui nous a présenté à nos clients en 1890, bien que plus tard par quelques jours de notre Cory, seront trouvés à dépasser l'un d'entre eux dans deux qualités très importantes : 1ère, elle a moins de charbon

RMRE1R0F–. La nature et le développement des plantes. La botanique. W A B Fig. i66. Fig. 167. Fig. 166. Un charbon commun, Ustilago, transformer les grains de maïs en noir de suie pustules. Fig. 167. La formation et la germination des spores de charbon l'un : un, la formation des spores de le mycélium dans le grain de maïs. B, la germination d'une spore et l'apparence de la basidiospore. des États-Unis dépasse 2 000 000 $ par année. Dans le cas du maïs, le parasite évolue au même rythme que la croissance de la plante sans produire de graves dommages jusqu'à ce que les fleurs apparaissent, lorsque le mycélium augmente fortement dans l'affecte

RMRDWFR5–. La nature et le développement des plantes. La botanique. B Fig. 166. Fig. 167. Fig. 166. Un charbon commun, Ustilago, transformer les grains de maïs en noir de suie pustules. Fig. 167. La formation et la germination des spores de charbon l'un : un, la formation des spores de le mycélium dans le grain de maïs. B, la germination d'une spore et l'apparence de la basidiospore. des États-Unis dépasse 2 000 000 $ par année. Dans le cas du maïs, le parasite évolue au même rythme que la croissance de la plante sans produire de graves dommages jusqu'à ce que les fleurs apparaissent, lorsque le mycélium augmente fortement dans l'ea

RMRDW9KA–. Manuel de botanique. La botanique. 386 Manuel de botanique. Fig. 219. partie de la sombre figure représente des masses de spores qui s'échappe. Le charbon com sont parfois aussi gros qu'un poing d'homme ; tiiey se produisent sur la tige, feuilles, racines ou, dans les oreilles ou dans les panicules. Une grande partie d'une oreille, ou même un ensemble de l'oreille, peut être remplacée par la masses noires. Le champignon qui cause la maladie est constitué de fils de branchement qui une oreille smutted de §»«^ 0 entre les cellules du maïs. Remarquez l'immense superficie plante hôte et envoyer branches du noyaux malades. Le ^^^^ ^-^^ ^^^ ^gijon q obtenir de la nourriture. Le champignon ne

RMRE1K52–. Des études de l'usine ; une école primaire la botanique. La botanique. BOOTS 107. L'approvisionnement en denrées alimentaires. Par conséquent, les processus sont élaborés qui pene- trate et absorber. Le gui et de graines de cuscute sont- des plantes qui ont cette h a b i t, une fois d'avoir de tels processus (voir fig. 103, 103). Cette habitude est beaucoup plus développé, cependant, dans un groupe de plantes, connu sous le nom de champignons. Plusieurs de ces champignons parasites vivent sur les plantes et les animaux, illustrations commun étant le mildiou des feuilles de lilas et beaucoup d'autres plantes, la rouille du blé, le charbon du maïs, etc. 70. Structure de la racine. -Dans le plus bas des groupes de plantes (un

RMRE88JD–. Les cultures de maïs : une discussion sur le maïs, et le sorgho comme kafirs, cultivé aux États-Unis et au Canada. Maïs, sorgho, maïs kafir. Et les semis précoce 189 variétés dent partager à propos de l'égalité de popularité avec le silex. Au-dessus de 1000 pieds d'altitude, pierres sont presque universels. Variétés typiques sont : - les variétés de silex huit rangs et douze rangs Silex jaune Philip King Canada Nez Charbon Hall's Gold Nugget variétés Dent Fierté de l'Amérique du bouchon blanc Début Huron diverses variétés locales acclimatés dans cette section, un tiers à une moitié du maïs est cultivé pour l'ensilage. À cette fin la semence

RMRE7T0M–. De plus en plus ; le maïs, de juger, de reproduction, d'alimentation, le marketing ;. Le maïs. Croissance d'STKMS 43 l'humidité de l'intérieur. En cours- lisse, il n'accorde aucune place pour le dépôt des spores de charbon. Les insectes des difficultés à l'insertion de leur bouche Sucer dans ces parties. (2) Le mur de Woody, qui est vraiment une couche composée d'une union étroite d'un grand nombre de fibro-lt ;'ascular les faisceaux. Dans les petits grains et herbes, ce mur woody est la seule structure d'appui dans la tige. À partir de chaque noeud, où une feuille se développe hors, un certain nombre de ces groupes de quitter le mur dans la feuille pour le nourrir. Le rang le plus gro

RMREW6C3–. M. Hess livre stock : un traité scientifique sur les chevaux, bovins, moutons, porcs et volailles. Les chevaux, la médecine vétérinaire. La nourriture pour un cheval doit al- façons être propres et exempts de poussière de charbon, Moule ou. La ration de grain ne devrait pas être limité à un seul article, comme le maïs ou d'avoine* Les meilleurs résultats sont obtenus à partir de la GIV- ant une variété de céréales, telles que l'avoine, le maïs, l'wheatbran et middlings, avec tourteau de lin à l'occasion. Blé n'est pas une forme souhaitable de la nourriture pour le cheval, comme il est susceptible de former la pâte et est assez difficile à digérer. Vert, les grains sont extrêmement mal guérie. Veuillez noter

RMRDXP8M–. Le jardin du débutant livre ; un manuel pour la partie supérieure de la grammaire. Le jardinage. 332 Liste de plantation est le ver gris, contre qui utilisent des appâts avant que les plantes sont en place. Sow tall sortes de collines, deux pieds sur quatre, et fines à trois ou quatre usines. Court-types peuvent être cultivées en rangs, environ trois pieds de distance, les plantes de 9 à 12 pouces à part dans les lignes. Cultiver souvent, mais pas profondément, et bien d'alimentation, avec la racine de la vinaigrette. Si le charbon apparaît, l'enflure et le noircissement des noyaux, les oreilles devraient être brûlés. Le maïs n'est pas prêt pour la table jusqu'à la soie est ratatinée et sec ; les oreilles sho

RMRDDYE3–. Les maladies des cultures et leurs remèdes : un manuel de biologie économique pour les agriculteurs et les étudiants. Les maladies des plantes. 100 LES MALADIES DU CEOPS. être imprégné d'une solution de sulfate de cuivre ou du sel commun. Le champignon (Ustilago carbo, fig. 39)- pro duces le bien-connu et flétri noir oreilles de com. Il attaque l'orge, le blé, et de certaines graminées, ainsi que l'avoine. La maladie est dite provenir dans les racines des plantes-hôtes, et transmet jusqu'les tiges dans les feuilles et. Fig. 39.-l'escarbille du maïs (Ustilago cario). A. OatB infestés par TJstilago carbo (a). B. '* Sori '* sur une partie d'une glume

RMRE3G2K–. De plus en plus ; le maïs, de juger, de reproduction, d'alimentation, le marketing ; pour l'agriculteur, étudiant et enseignant de l'agriculture, un manuel pour l'enseignement agricole et des shcools. Le maïs. GR()'TH DE TIGES 43 l'humidité de l'intérieur. C'est lisse, afl'adr pas de place pour le dépôt des spores de charbon. Les insectes des difficultés à l'insertion de leur bouche Sucer dans ces parties. (2) Le mur de Woody, qui est vraiment une couche composée d'une union étroite d'un grand nombre de fibro-faisceaux vasculaires. Dans les petits grains et herbes, ce mur woody est la seule structure d'appui dans la tige. À partir de chaque noeud, où une feuille gro

RMRDW9K7–. Manuel de botanique. La botanique. Fig. 219. partie de la sombre figure représente des masses de spores qui s'échappe. Le charbon com sont parfois aussi gros qu'un poing d'homme ; tiiey se produisent sur la tige, feuilles, racines ou, dans les oreilles ou dans les panicules. Une grande partie d'une oreille, ou même un ensemble de l'oreille, peut être remplacée par la masses noires. Le champignon qui cause la maladie est constitué de fils de branchement qui une oreille smutted de §»«^ 0 entre les cellules du maïs. Remarquez l'immense superficie plante hôte et envoyer branches du noyaux malades. Le ^^^^ ^-^^ ^^^ ^gijon q obtenir de la nourriture. Le champignon ne tue pas l'hôte cel

RMRDGX40–. Les maladies des cultures et leurs remèdes : un manuel de biologie économique pour les agriculteurs et les étudiants. Les maladies des plantes. 100 LES MALADIES DU CBOPS. être imprégné d'une solution de sulfate de cuivre ou du sel commun. Le {champignon Ustilago carbo, fig. 39)- pro duces le bien-connu et flétri noir oreilles de maïs. Il attaque l'orge, le blé, et de certaines graminées, ainsi que l'avoine. La maladie est dite provenir dans les racines des plantes-hôtes, et transmet jusqu'les tiges dans les feuilles et. Fig. 39.-l'Escarbille op [Coen Ustilago carbo). A. L'avoine infestés par Ustilago carbo (a). B. " Sori" sur une partie de
![. [Catalogue] : printemps 1962. Pépinières (Horticulture) Caroline du Nord Raleigh catalogues ; pépinière Raleigh en Caroline du Nord Caroline du Nord ; semences Catalogues Catalogues de Raleigh, Caroline du Nord (plantes) Catalogues de Raleigh de Raleigh en Caroline du Nord ; légumes ; Jardinage Catalogues Nort. 243 Aristogold ArkfnnnM^ 74 ^^^»^ ^8 à 10 grands à MriSTOgOia po, jaune d'épis de maïs Sucre délicieusement doux 16 à 18 lignes par s/n. Un hybride à haut rendement d'énergie produisant de grandes cultures pour les producteurs commerciaux qui apprécient sa haute qualit.c. rendement et la résistance à l'ear-ver et charbon. 88 jours. Pkt. Banque D'Images . [Catalogue] : printemps 1962. Pépinières (Horticulture) Caroline du Nord Raleigh catalogues ; pépinière Raleigh en Caroline du Nord Caroline du Nord ; semences Catalogues Catalogues de Raleigh, Caroline du Nord (plantes) Catalogues de Raleigh de Raleigh en Caroline du Nord ; légumes ; Jardinage Catalogues Nort. 243 Aristogold ArkfnnnM^ 74 ^^^»^ ^8 à 10 grands à MriSTOgOia po, jaune d'épis de maïs Sucre délicieusement doux 16 à 18 lignes par s/n. Un hybride à haut rendement d'énergie produisant de grandes cultures pour les producteurs commerciaux qui apprécient sa haute qualit.c. rendement et la résistance à l'ear-ver et charbon. 88 jours. Pkt. Banque D'Images](https://c8.alamy.com/compfr/rf3j6d/catalogue-printemps-1962-pepinieres-horticulture-caroline-du-nord-raleigh-catalogues-pepiniere-raleigh-en-caroline-du-nord-caroline-du-nord-semences-catalogues-catalogues-de-raleigh-caroline-du-nord-plantes-catalogues-de-raleigh-de-raleigh-en-caroline-du-nord-legumes-jardinage-catalogues-nort-243-aristogold-arkfnnnm-74-8-a-10-grands-a-mristogoia-po-jaune-d-epis-de-mais-sucre-delicieusement-doux-16-a-18-lignes-par-s-n-un-hybride-a-haut-rendement-d-energie-produisant-de-grandes-cultures-pour-les-producteurs-commerciaux-qui-apprecient-sa-haute-qualit-c-rendement-et-la-resistance-a-l-ear-ver-et-charbon-88-jours-pkt-rf3j6d.jpg)
RMRF3J6D–. [Catalogue] : printemps 1962. Pépinières (Horticulture) Caroline du Nord Raleigh catalogues ; pépinière Raleigh en Caroline du Nord Caroline du Nord ; semences Catalogues Catalogues de Raleigh, Caroline du Nord (plantes) Catalogues de Raleigh de Raleigh en Caroline du Nord ; légumes ; Jardinage Catalogues Nort. 243 Aristogold ArkfnnnM^ 74 ^^^»^ ^8 à 10 grands à MriSTOgOia po, jaune d'épis de maïs Sucre délicieusement doux 16 à 18 lignes par s/n. Un hybride à haut rendement d'énergie produisant de grandes cultures pour les producteurs commerciaux qui apprécient sa haute qualit.c. rendement et la résistance à l'ear-ver et charbon. 88 jours. Pkt.

RMRF7JH3–. Catalogue de semences de Bell : les meilleures et les moins chers dans les graines. Pépinière New York (État) ; Catalogues Catalogues ; Graines de légumes graines de fleurs bulbes ; Catalogues Catalogues (plantes). JnIORTHERN GROWjN HyRDY, vigoureux.. Domaine de notre chant d'Evergreen pour la semence. Nouveau début de Sheffield le maïs sucré. Croisement entre le début de l'Adams et Cory faisant également comme hardy et antérieure à l'Adams et possédant la douceur de Cory et absolument les noyaux Smut-Drcof arrarsred de taille moyenne et bien sur à à 12 rangs oreilles 6 pouces de long ; d'une saveur sucrée en délire. Essayez ceci pour un bon début de com. 34 pinte 7cts. 3*£pt. 1

RMRF6M4C–. La page : annuel de semences semences, bulbes, plantes, roses, les arbres fruitiers, la vigne. Pépinière New York (État) ; Catalogues Catalogues ; Graines de légumes graines de fleurs Plantes ornementales ; catalogues, catalogues de graines de graminées ; catalogues. 264.* Début de la perfection, une nouvelle variété de maïs doux qui vient d'être présenté et, par essais, se trouve être un excellent choix. Les tiges sont fortes et vigoureuses, croître de près de 5 pieds de haut et produisant de grandes oreilles entièrement à l'abri de charbon, bien rempli de 10 à 12 rangées de .juteux, doux, très bien assaisonné de maïs. Nous recommandons à tous nos clients d'essayer au moins une petite quantité de ce sw

RMRDG074–. Les cultures de maïs : une discussion sur le maïs, et le sorgho comme kafirs, cultivé aux États-Unis et au Canada. Maïs, sorgho, maïs kafir. Et les semis précoce 189 variétés dent partager à propos de l'égalité de popularité avec le silex. Au-dessus de 1000 pieds d'altitude, pierres sont presque universels. Variétés de silex huit rangs et douze rangs Silex jaune Nez Phihp Roi Charbon Canada variétés Dent Fierté de l'Amérique du bouchon blanc Hall's Gold Nugget diverses variétés acclimatées dans cette section locale, un tiers à une moitié du maïs est cultivé pour l'ensilage. À cet effet, la semence est habituellement. Fig. 54. - Quatre oreilles en cen
![. [Catalogue] : printemps 1957. Pépinières (Horticulture) Caroline du Nord Raleigh catalogues ; pépinière Raleigh en Caroline du Nord Caroline du Nord ; semences Catalogues Catalogues de Raleigh, Caroline du Nord (plantes) Catalogues de Raleigh de Raleigh en Caroline du Nord ; légumes ; Jardinage Catalogues Nort. 243 Aristogold Aristogold 243 Maïs, folI^^Tlitc n 8 à 10 pouces. " Les oreilles de bas de- liciously com sucre sucré 16 à 18 lignes par s/n. Un hybride à haut rendement d'énergie produisant de grandes cultures pour les producteurs commerciaux qui apprécient la grande qualité, le rendement et la résistance à l'ear-ver et charbon. 88 jours. Pkt. 20c ; H lb. 50c ; Banque D'Images . [Catalogue] : printemps 1957. Pépinières (Horticulture) Caroline du Nord Raleigh catalogues ; pépinière Raleigh en Caroline du Nord Caroline du Nord ; semences Catalogues Catalogues de Raleigh, Caroline du Nord (plantes) Catalogues de Raleigh de Raleigh en Caroline du Nord ; légumes ; Jardinage Catalogues Nort. 243 Aristogold Aristogold 243 Maïs, folI^^Tlitc n 8 à 10 pouces. " Les oreilles de bas de- liciously com sucre sucré 16 à 18 lignes par s/n. Un hybride à haut rendement d'énergie produisant de grandes cultures pour les producteurs commerciaux qui apprécient la grande qualité, le rendement et la résistance à l'ear-ver et charbon. 88 jours. Pkt. 20c ; H lb. 50c ; Banque D'Images](https://c8.alamy.com/compfr/rf2p8f/catalogue-printemps-1957-pepinieres-horticulture-caroline-du-nord-raleigh-catalogues-pepiniere-raleigh-en-caroline-du-nord-caroline-du-nord-semences-catalogues-catalogues-de-raleigh-caroline-du-nord-plantes-catalogues-de-raleigh-de-raleigh-en-caroline-du-nord-legumes-jardinage-catalogues-nort-243-aristogold-aristogold-243-mais-foli-tlitc-n-8-a-10-pouces-les-oreilles-de-bas-de-liciously-com-sucre-sucre-16-a-18-lignes-par-s-n-un-hybride-a-haut-rendement-d-energie-produisant-de-grandes-cultures-pour-les-producteurs-commerciaux-qui-apprecient-la-grande-qualite-le-rendement-et-la-resistance-a-l-ear-ver-et-charbon-88-jours-pkt-20c-h-lb-50c-rf2p8f.jpg)
RMRF2P8F–. [Catalogue] : printemps 1957. Pépinières (Horticulture) Caroline du Nord Raleigh catalogues ; pépinière Raleigh en Caroline du Nord Caroline du Nord ; semences Catalogues Catalogues de Raleigh, Caroline du Nord (plantes) Catalogues de Raleigh de Raleigh en Caroline du Nord ; légumes ; Jardinage Catalogues Nort. 243 Aristogold Aristogold 243 Maïs, folI^^Tlitc n 8 à 10 pouces. " Les oreilles de bas de- liciously com sucre sucré 16 à 18 lignes par s/n. Un hybride à haut rendement d'énergie produisant de grandes cultures pour les producteurs commerciaux qui apprécient la grande qualité, le rendement et la résistance à l'ear-ver et charbon. 88 jours. Pkt. 20c ; H lb. 50c ;

RMRF3NMK–. Catalogue 1963. L'industrie des semences et les catalogues commerciaux ; catalogues ; Graines Graines Graines fruits ; Catalogues Catalogues ; Matériel et fournitures de jardinage ; Catalogues Catalogues de graines de fleurs. Jardin du maïs. GOLDEN BANTAM BANTAM Maïs sucre : ARJSTOGOLD-83 jours. Un vrai aristocrate de la douce com hybrides. De plus en plus rapide, permet des rendements exceptionnels, même dans les saisons chaudes, drouthy, parce qu'il se trouve au début de la plantation dans le sol froid et humide. A une grande résistance à l'escarbille et ver de dommages. Branches de 8 à 9 pi. de hauteur et les oreilles très grands avec 12 à 14 lignes. Doux, tendre et délicieux. GOLDEN BANTAM-88 jours. Plus largement connu début

RMRF7JGR–. Catalogue de semences de Bell : les meilleures et les moins chers dans les graines. Pépinière New York (État) ; Catalogues Catalogues ; Graines de légumes graines de fleurs bulbes ; Catalogues Catalogues (plantes). Domaine de notre chant d'Evergreen pour la semence. Nouveau début de Sheffield le maïs sucré. Croisement entre le début de l'Adams et Cory faisant également comme hardy et antérieure à l'Adams et possédant la douceur de Cory et absolument les noyaux Smut-Drcof arrarsred de taille moyenne et bien sur à à 12 rangs oreilles 6 pouces de long ; d'une saveur sucrée en délire. Essayez ceci pour un bon début de com. 34 pinte 7cts. 3*£pt. 12c pinte 38 cts. Bv express qt. 22c.
![. [Catalogue] : printemps 1961. Pépinières (Horticulture) Caroline du Nord Raleigh catalogues ; pépinière Raleigh en Caroline du Nord Caroline du Nord ; semences Catalogues Catalogues de Raleigh, Caroline du Nord (plantes) Catalogues de Raleigh de Raleigh en Caroline du Nord ; légumes ; Jardinage Catalogues Nort. 243 Aristogold Aricfrtnnl^ 74/H Très grand 8 à 10 pouces, ^^ alugUlU '"'jaune d'oreilles de de- liciously sucre sucré 16 maïs à 18 lignes par s/n. Un hybride à haut rendement d'énergie produisant de grandes cultures pour les producteurs commerciaux qui apprécient la grande qualité, le rendement et la résistance à l'ear-ver et charbon, 88 jours Banque D'Images . [Catalogue] : printemps 1961. Pépinières (Horticulture) Caroline du Nord Raleigh catalogues ; pépinière Raleigh en Caroline du Nord Caroline du Nord ; semences Catalogues Catalogues de Raleigh, Caroline du Nord (plantes) Catalogues de Raleigh de Raleigh en Caroline du Nord ; légumes ; Jardinage Catalogues Nort. 243 Aristogold Aricfrtnnl^ 74/H Très grand 8 à 10 pouces, ^^ alugUlU '"'jaune d'oreilles de de- liciously sucre sucré 16 maïs à 18 lignes par s/n. Un hybride à haut rendement d'énergie produisant de grandes cultures pour les producteurs commerciaux qui apprécient la grande qualité, le rendement et la résistance à l'ear-ver et charbon, 88 jours Banque D'Images](https://c8.alamy.com/compfr/rf2r39/catalogue-printemps-1961-pepinieres-horticulture-caroline-du-nord-raleigh-catalogues-pepiniere-raleigh-en-caroline-du-nord-caroline-du-nord-semences-catalogues-catalogues-de-raleigh-caroline-du-nord-plantes-catalogues-de-raleigh-de-raleigh-en-caroline-du-nord-legumes-jardinage-catalogues-nort-243-aristogold-aricfrtnnl-74-h-tres-grand-8-a-10-pouces-alugulu-jaune-d-oreilles-de-de-liciously-sucre-sucre-16-mais-a-18-lignes-par-s-n-un-hybride-a-haut-rendement-d-energie-produisant-de-grandes-cultures-pour-les-producteurs-commerciaux-qui-apprecient-la-grande-qualite-le-rendement-et-la-resistance-a-l-ear-ver-et-charbon-88-jours-rf2r39.jpg)
RMRF2R39–. [Catalogue] : printemps 1961. Pépinières (Horticulture) Caroline du Nord Raleigh catalogues ; pépinière Raleigh en Caroline du Nord Caroline du Nord ; semences Catalogues Catalogues de Raleigh, Caroline du Nord (plantes) Catalogues de Raleigh de Raleigh en Caroline du Nord ; légumes ; Jardinage Catalogues Nort. 243 Aristogold Aricfrtnnl^ 74/H Très grand 8 à 10 pouces, ^^ alugUlU '"'jaune d'oreilles de de- liciously sucre sucré 16 maïs à 18 lignes par s/n. Un hybride à haut rendement d'énergie produisant de grandes cultures pour les producteurs commerciaux qui apprécient la grande qualité, le rendement et la résistance à l'ear-ver et charbon, 88 jours

RMRDXT77–. Un manuel de plantes toxiques, principalement de l'Est de l'Amérique du Nord, avec de brèves notes sur le développement économique et les plantes médicinales, et de nombreuses illustrations. Plantes toxiques. Manuel 2h de plantes toxiques. Fig. 55a. 1. La germination de l'herbe (charbon Ustilago panici-miliacei) montrant les grands de l'enflure dans la partie de la plante. C. M. King. 2. Vollmer - lUstilago charbon Millet). a, b, les spores ; glumes â¢de grains de mil rempli d'un powderjr masse de spores. C. M. King. 3. Grain de maïs ( charbon, Ustilago fischeri) sur le maïs. Spores à droite. Ci-dessous une vue en coupe d'un noyau. Pammel et Roi.  les bovins. Les expériences

RMRF3NMC–. Catalogue 1963. L'industrie des semences et les catalogues commerciaux ; catalogues ; Graines Graines Graines fruits ; Catalogues Catalogues ; Matériel et fournitures de jardinage ; Catalogues Catalogues de graines de fleurs. GOLDEN BANTAM BANTAM Maïs sucre : ARJSTOGOLD-83 jours. Un vrai aristocrate de la douce com hybrides. De plus en plus rapide, permet des rendements exceptionnels, même dans les saisons chaudes, drouthy, parce qu'il se trouve au début de la plantation dans le sol froid et humide. A une grande résistance à l'escarbille et ver de dommages. Branches de 8 à 9 pi. de hauteur et les oreilles très grands avec 12 à 14 lignes. Doux, tendre et délicieux. GOLDEN BANTAM-88 jours. Plus largement connu variété précoce, gro
![. Minnesota maladies des plantes. Les maladies des plantes. Minnesota Maladies des Plantes. 393 arrondi par une couche de spores plus petites, plus légères, qui ont perdu leur pouvoir de germination. Les balles s'échapper des spores intactes comme la poudre de charbon. Charbon Carnation [UsHlago {P. violacea) Fckl.]. Ce charbon est souvent trouvé sur les plantes sauvages de la famille rose ; e. g., sur des mauvaises herbes, starworts-, attrape-mouches, soapworts le maïs et les coques. Voir des émissions de maladies et plantes ornementales.. Fig. 209.-menthe la rouille. Les grappes de spores d'hiver sur les feuilles. L'original. Violet de charbon [Urocystis violae (Sow.) Fisch.]. L'un oc- casionally répond aux Banque D'Images . Minnesota maladies des plantes. Les maladies des plantes. Minnesota Maladies des Plantes. 393 arrondi par une couche de spores plus petites, plus légères, qui ont perdu leur pouvoir de germination. Les balles s'échapper des spores intactes comme la poudre de charbon. Charbon Carnation [UsHlago {P. violacea) Fckl.]. Ce charbon est souvent trouvé sur les plantes sauvages de la famille rose ; e. g., sur des mauvaises herbes, starworts-, attrape-mouches, soapworts le maïs et les coques. Voir des émissions de maladies et plantes ornementales.. Fig. 209.-menthe la rouille. Les grappes de spores d'hiver sur les feuilles. L'original. Violet de charbon [Urocystis violae (Sow.) Fisch.]. L'un oc- casionally répond aux Banque D'Images](https://c8.alamy.com/compfr/rde318/minnesota-maladies-des-plantes-les-maladies-des-plantes-minnesota-maladies-des-plantes-393-arrondi-par-une-couche-de-spores-plus-petites-plus-legeres-qui-ont-perdu-leur-pouvoir-de-germination-les-balles-s-echapper-des-spores-intactes-comme-la-poudre-de-charbon-charbon-carnation-ushlago-p-violacea-fckl-ce-charbon-est-souvent-trouve-sur-les-plantes-sauvages-de-la-famille-rose-e-g-sur-des-mauvaises-herbes-starworts-attrape-mouches-soapworts-le-mais-et-les-coques-voir-des-emissions-de-maladies-et-plantes-ornementales-fig-209-menthe-la-rouille-les-grappes-de-spores-d-hiver-sur-les-feuilles-l-original-violet-de-charbon-urocystis-violae-sow-fisch-l-un-oc-casionally-repond-aux-rde318.jpg)
RMRDE318–. Minnesota maladies des plantes. Les maladies des plantes. Minnesota Maladies des Plantes. 393 arrondi par une couche de spores plus petites, plus légères, qui ont perdu leur pouvoir de germination. Les balles s'échapper des spores intactes comme la poudre de charbon. Charbon Carnation [UsHlago {P. violacea) Fckl.]. Ce charbon est souvent trouvé sur les plantes sauvages de la famille rose ; e. g., sur des mauvaises herbes, starworts-, attrape-mouches, soapworts le maïs et les coques. Voir des émissions de maladies et plantes ornementales.. Fig. 209.-menthe la rouille. Les grappes de spores d'hiver sur les feuilles. L'original. Violet de charbon [Urocystis violae (Sow.) Fisch.]. L'un oc- casionally répond aux

RMRDE0D2–. Les maladies des cultures et leur contrôle du chariot . Les légumes. Fig. 45. Le maïs sucré Maladies. a. La brûlure bactérienne, 6. les organismes bactérien (a. à 6. après F. C. Stewart), c.. d. les spores du charbon, e. et/, spores en germination de l'Ustilago zem (d. à/, d'après J. B. S. Norton).. Veuillez noter que ces images sont extraites de la page numérisée des images qui peuvent avoir été retouchées numériquement pour plus de lisibilité - coloration et l'aspect de ces illustrations ne peut pas parfaitement ressembler à l'œuvre originale.. Taubenhaus Jacob, Joseph, 1884-1937. New York : E. P. Dutton & ; Co.

RMRDDCM7–. Les cultures de maïs : une discussion sur le maïs, et le sorgho comme kafirs, cultivé aux États-Unis et au Canada. Maïs, sorgho, maïs kafir. Animaux et d'INSECTES ENNEMIS 219. Fig. 73. - Épis de maïs montrant.. Veuillez noter que ces images sont extraites de la page numérisée des images qui peuvent avoir été retouchées numériquement pour plus de lisibilité - coloration et l'aspect de ces illustrations ne peut pas parfaitement ressembler à l'œuvre originale.. Montgomery, Edward Gerrard, 1878-. New York, The Macmillan Company

RMRDYHDT–. Le livre de champignons : un guide populaire pour l'identification et l'étude de nos champignons roturier, avec un accent particulier sur la variétés comestibles . Les champignons, les champignons comestibles, de cuisine ; (champignons) ; cbk. Le charbon du maïs. La rouille sur Hepaiica triloba. Veuillez noter que ces images sont extraites de la page numérisée des images qui peuvent avoir été retouchées numériquement pour plus de lisibilité - coloration et l'aspect de ces illustrations ne peut pas parfaitement ressembler à l'œuvre originale.. Marshall, Nina L. (Nina Lovering). New York : Doubleday, Page

RMRDXT7B–. Un manuel de plantes toxiques, principalement de l'Est de l'Amérique du Nord, avec de brèves notes sur le développement économique et les plantes médicinales, et de nombreuses illustrations. Plantes toxiques. Fig. 55. 1. Le charbon du maïs (Ustilago seae). Montrant les cellules de mycélium de thread en passant de cellule en cellule ; (a) thread montre throiigh ; (b) l'article de couper la gaine et fil. 2. Le charbon du maïs, les spores dans les processus de germination ; chaque spore est l'envoi d'un tube de petits organes multilatéraux. 3. La même, en germination des spores en solution nutritive germination à des levures. U. de S. Dept. Agr. 4. Escarbille du grain de sorgho {Spkaceiolheca S.>rshi) sur le sorgho.. P

RMRDWFRC–. La nature et le développement des plantes. La botanique. 258 FORMES DE SMUTS liés. Ils produisent de manière très générale, mais une forme de spore que peut éventuellement être comparée à la téliospore. Ils sont com- mun et extrêmement destructeurs de parasites, notamment des fleurs et fruits de maïs et autres céréales que le blé, l'avoine et l'orge (Fig. i66)'. Les dommages par smuts à la récolte de maïs. Veuillez noter que ces images sont extraites de la page numérisée des images qui peuvent avoir été retouchées numériquement pour plus de lisibilité - coloration et l'aspect de ces illustrations ne peut pas parfaitement ressembler à l'œuvre originale.. Curt

RMRDXT6K–. Un manuel de plantes toxiques, principalement de l'Est de l'Amérique du Nord, avec de brèves notes sur le développement économique et les plantes médicinales, et de nombreuses illustrations. Plantes toxiques. EUTHALLEPHYTA-EUMYCETES-SMUTS 219 M. W. A. Kelty m'informe que l'escarbille renouées {Ustilago utriculosa) produit souvent une grave irritation des mains lorsque le maïs est riz décortiqué. TutETiACBAE, mycélium Schrot gélatinisé devenir dans les tissus ; le promycélium donne lieu au terminal de cluster ou fusible allongées qui sporidies ne fusionnent pas en paires, produisant des sporidies secondaires qui peuvent être semblables ou unlik6, ou la germination sporidies dir

RMRDWBRJ–. Les plantes ; un texte-livre de botanique. La botanique. L'approvisionnement en denrées alimentaires. Par conséquent, les processus sont élaborés qui pene- trate et absorber. Le gui et de graines de cuscute sont- "plantes qui ont cette habitude, et les deux ont de tels processus (voir fig. 102, 103). Cette habitude est beaucoup plus développé, cependant, dans un groupe de plantes, connu sous le nom de champignons. ilany de ces champignons parasites vivent sur les plantes et les animaux, illustrations commun étant le mildiou des feuilles de lilas et beaucoup d'autres plantes, la rouille du blé, le charbon du maïs, etc.. Structuie racine. -Dans le plus bas des groupes de plantes (algffi, champignons, un

RMRDWBRP–. Les plantes ; un texte-livre de botanique. La botanique. Les racines. 107. L'approvisionnement en denrées alimentaires. Par conséquent, les processus sont élaborés qui pene- trate et absorber. Le gui et de graines de cuscute sont- "plantes qui ont cette habitude, et les deux ont de tels processus (voir fig. 102, 103). Cette habitude est beaucoup plus développé, cependant, dans un groupe de plantes, connu sous le nom de champignons. ilany de ces champignons parasites vivent sur les plantes et les animaux, illustrations commun étant le mildiou des feuilles de lilas et beaucoup d'autres plantes, la rouille du blé, le charbon du maïs, etc.. Structuie racine. -Dans le plus bas des groupes de plantes (algf

RMRE1K4X–. Des études de l'usine ; une école primaire la botanique. La botanique. L'approvisionnement en denrées alimentaires. Par conséquent, les processus sont élaborés qui pene- trate et absorber. Le gui et de graines de cuscute sont- des plantes qui ont cette h a b i t, une fois d'avoir de tels processus (voir fig. 103, 103). Cette habitude est beaucoup plus développé, cependant, dans un groupe de plantes, connu sous le nom de champignons. Plusieurs de ces champignons parasites vivent sur les plantes et les animaux, illustrations commun étant le mildiou des feuilles de lilas et beaucoup d'autres plantes, la rouille du blé, le charbon du maïs, etc. 70. Structure de la racine. -Dans le plus bas des groupes de plantes (algues, champignons ?

RMRDHH94–. Des études de l'usine ; une école primaire la botanique. La botanique. 107 racines. L'approvisionnement en denrées alimentaires. T h e r g f o r o, p r o - cesse sont mis "qui pene- trate et aliscirh. Le gui et de graines de cuscute sont- "les plantes qui ont t h i s h a Ij. a n d les deux ont de tels processus (voir fig. 102, 103). Cette habitude est plus mncli largement développé, cependant, dans un groupe de plantes, connu sous le nom de champignons. Plusieurs de ces champignons iiarasitic jilants sur live et d'animaux, illustrations commun étant le mildiou des feuilles de lilas et beaucoup d'autres plantes, la rouille du blé, l'escarbille i:si le maïs, etc. 70. Structure de la racine.

RMRDHH8M–. Des études de l'usine ; une école primaire la botanique. La botanique. L'approvisionnement en denrées alimentaires. T h e r g f o r o, p r o - cesse sont mis "qui pene- trate et aliscirh. Le gui et de graines de cuscute sont- "les plantes qui ont t h i s h a Ij. a n d les deux ont de tels processus (voir fig. 102, 103). Cette habitude est plus mncli largement développé, cependant, dans un groupe de plantes, connu sous le nom de champignons. Plusieurs de ces champignons iiarasitic jilants sur live et d'animaux, illustrations commun étant le mildiou des feuilles de lilas et beaucoup d'autres plantes, la rouille du blé, l'escarbille i:si le maïs, etc. 70. Structure de la racine. -Dans le bas